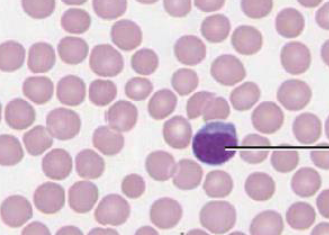
<p>blood</p>

1/80
Looks like no tags are added yet.
Name | Mastery | Learn | Test | Matching | Spaced | Call with Kai |
|---|
No analytics yet
Send a link to your students to track their progress
lab safety rules
minimize exposure to chemicals and hazards
report medical conditions or concerns
know hazards and follow safety data instructions
unauthorized work is prohibited
no food or drinks in lab
wear PPE
avoid contacts
know safety equipment and emergency locations
stay alert and be aware
report accidents immediately
keep workplace clean
follow additional rules
call 911 or campus police for emergencies

squamous
flat shaped cell

cubodial
cube shaped cell

columnar
rectangular shaped cell

simple
one layer

stratified
two or more layers

pseudostratified
one layer but it looks like more

areolar tissue
general binding found in the skin and muscle

adipose tissue
made up of fat cells, energy storage

reticular tissue
contains reticular fibers, provides a supportive framework for soft organs

dense regular connective tissue
make up tendons and ligaments; fibers in parallel bundles

dense irregular connective tissue
fibers interwoven into a mesh; strength

hyaline cartilage
provides support with some flexibility; trachea, nose

fibrocartilage
provides some compressibility, shock absorber; between vertebrae

elastic cartilage
provides firm but elastic support; ear

skeletal muscle
Voluntary movement, produces heat, protects organs; striations

cardiac muscle
Contracts to pump blood; striations and intercalated discs

smooth muscle
Involuntary movement, moves food, involuntary control of respiration, moves secretions,
regulates flow of blood in arteries by contraction; no striations
blood
?
lymph
?

neuron
communcation

cell body
regular cell jobs, organelles

dendrites
receive messages from neurons

axons
send out messages to other neurons
transcription
DNA to mRNA; in nucleus
translation
mRNA to protein; in cytoplasm
tRNA
grab amino acids to put together protein

codon
groups of three bases
depolarization
become really positive
repolarization
becomes negative
hyperpolarization
become extra negative
threshold
-55 mv
resting membrane potential (RMP)
-70 mv

steps of action potential
depolarization, repolarization, and hyperpolarization
two point threshold
minimum distance we still felt two points, two receptors talked to
sensory pathway
sensory receptor
dorsal root ganglia
up the spine
thalamus
sensory cortex
motor pathway
motor cortex
down the spine
ventral root ganglia
motor neuron
simple reflex response
spine only; knee jerk
complex reflex response
fast and involuntary; withdrawal reflex
autonomic reflex response
unaware regulation; pupillary light reflex
reaction time
time taken to process sensory information and react with motor information
sympathetic system
fight or flight, stress
parasympathetic
rest and digest
somatic reflex
knee jerk
isotonic
moving object
isometric
pushing against immovable object
type I slow twitch
resistant to fatigue; posture and walking; aerobic, lots of myoglobin - red
type IIb glycolytic
quick movement; anaerobic, little myoglobin - white
type IIa oxidative glycolytic
quick movement; aerobic
myofilaments
increase with exercise; dominant arm has more than non-dom
when weight training, do muscle cell size or number increase
cell size
prolactin
milk letdown
ACTH
stimulates release of cortisol
TSH
stimulates thyroid hormone release
GH
growth and repair
LH
stimulates release of sex hormones
FSH
stimulating development and maturation of sex cells
atrophy
gland grows smaller, underproducing
hypertrophy
gland grows bigger, overproducing
negative feedback
self-regulating mechanism where high levels of a hormone inhibit further production, maintaining homeostasis
I’m not explaining all the steps of reading a blood test
if the blood clots, it’s positive
erythroblastosis fetalis
when a Rh- mother has a Rh+ baby which causes antibodies to form against babies blood
why is blood compatibility important
antibodies will attack if blood is not compatible
cardiac output
heart rate × stroke volume
know how to measure blood pressure. i’m also not writing this
use a sphygmomanometer
systolic pressure
pressure when heart contracts
diastolic pressure
pressure when heart relaxes
hypertension
high BP
hypotension
low BP
how to measure % saturation
use a pulse ox
cillia
hairlike projections, moves mucus up to cough it out
goblet cells
produce mucus, traps germs and dust

what % saturation of oxygen is in our tissues
around 75%

what % saturation of oxygen is in our lungs
around 98-100%
spirometer
used to measure how well your lungs work by calculating the volume and speed of air you can inhale and exhale
tidal volume
amount of air inhaled and exhaled per breath during unforced quiet breathing
inspiratory reserve volume
volume inspired above tidal volume
expiratory reserve volume
volume expired forcefully after the end of normal expiration
residual volume
remaining air after maximum exhalation
vital capacity
amount of air forcefully exhaled after maximum inhale
total lung capacity
vital capacity + the residual volume